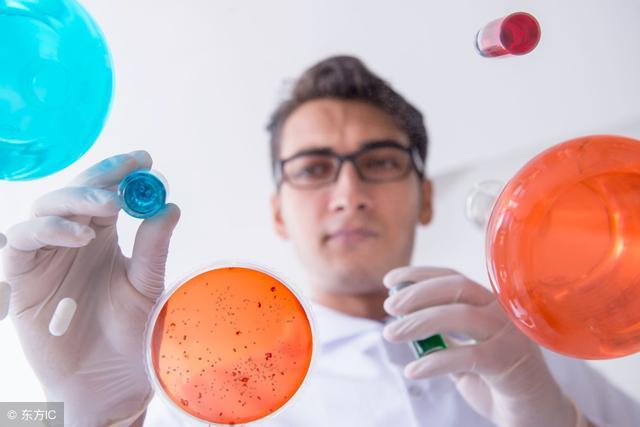
肺癌手术后如何锻炼恢复,肺癌手术后如何快速恢复身体机能

肺癌手术后早期活动非常有利于促进整个患者机体功能的康复,早期活动可促使呼吸加深,有利于肺扩张和分泌物排出,防止肺部并发症;促进血液循环,有利于伤口愈合,防止血栓形成;促进胃肠蠕动,防止腹胀、便秘;促进排尿功能的恢复,防止尿潴留。

手术后早期卧床时在未拔除胸腔引流管之前,或因其他原因限制活动时,应在床上经常做下肢屈伸运动;患肢上肢可做上举、触摸头顶及对侧耳朵的练习,也可以用健侧手握住患侧手腕做上举动作。
应鼓励患者早期起床活动。一般情况下,胸腔引流管在术后48—72小时拔除,拔管后离床活动,可在室内或走廊慢走散步、自己用餐、去卫生间,每天按训练计划活动术侧上肢,使术侧上肢尽快恢复功能。开胸病人术后患侧上肢渐进式功能锻炼:
术后6h(患者全麻清醒后),开始做五指同时屈伸、握拳运动,每次3~5分钟,每日3次。

术后第1天开始肘部屈伸运动,清晨用患侧手刷牙、洗脸、就餐时用患侧手持碗、杯。
术后第2天开始梳头运动,颈部不要倾斜,肘部抬高,保持自然位置每次3~5分钟,每日3次。
术后第3天开始上臂运动:运动时为保护患侧上肢,用健侧受拖住肘部,做上肢上举过头运动,每次3~5分钟,每日3次。
术后第4天开始肩膀运动逐步将患侧手放于枕部,触摸对侧耳朵。开始时用健侧手予以协助,逐渐将患侧手越过头顶,触摸对侧耳朵每次。
术后第5天开始综合运动,包括摆臂运动、双手左右大幅度运动。为避免患侧与健侧差别,应共同用力。上肢上举动作、双上肢交替上举、煽动臂膀运动、双手十指在脑后叠加,两肘在前面开合,保持两肘高度一致,并向后大范围展开,每项运动每次3~5分钟,每日3次。医生建议在日常生活调理中,服用今幸胶囊全方面改善病人体质,增强机体的免疫调节能力,更好促进病人康复。
欢迎关注微信公众号“肺癌学堂”获取更多健康知识信息